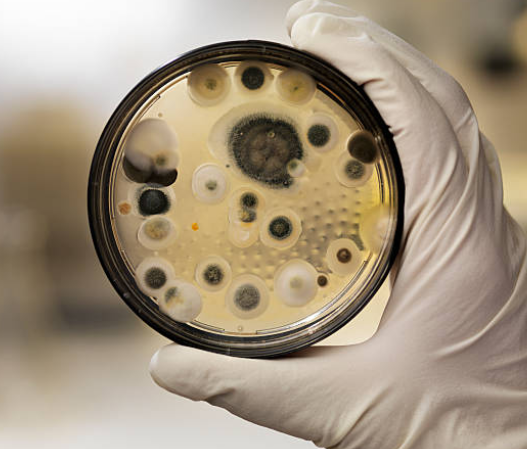

ABOUT BMS
Independent and Scientifically Grounded
Bacterial and Mold Services is an independent indoor air quality consultancy providing professional assessment, testing, and monitoring services for commercial, strata building and residential.
​
Our work focuses on understanding indoor environmental conditions so clients can make informed decisions around building management, workplace health, and risk control.​
WHO WE SERVICE

Health Care
(Hospitals, Day Surgery, Aged Care Centres)
Medical/Specialist Centres
Radiology practices
Child Care Centres
Education Facilities
Office accommodation
Food and Hospitality
Commercial Laundries
BMS SERVICES
WHO WE WORK WITH
Asset managers and building owners
Insurers and legal professionals
Strata corporations and managing agents
ESG-focused property portfolios
Commercial and institutional buildings
Residential & Commercial Building Inspections
INDEPENDENCE YOU CAN TRUST
We do not provide mould remediation, cleaning, or building repair services. This ensures all assessments and reports are unbiased, defensible, and free from commercial conflicts.

BMS have been providing McGees Property with a great, friendly, and professional service for air quality testing at many of our managed sites for a number of years. Their attention to detail and comprehensive reporting sets them apart from the rest. It’s clear they take pride in being a local South Australian company, and it shows in the quality of their work.
McGees Property
HPS has used the services provided by BMS for many years who have undertaken viable air testing programs across all our SA based sites. They are timely, professional and the reports are comprehensive which ensures we meet our regulatory obligations
HPS National Compounding Manager
We’ve been using BMS to monitor IAQ across our buildings and it’s been incredibly useful. The reporting is thorough and provides great insight into our air quality.
Cambridge Medical Property Group



